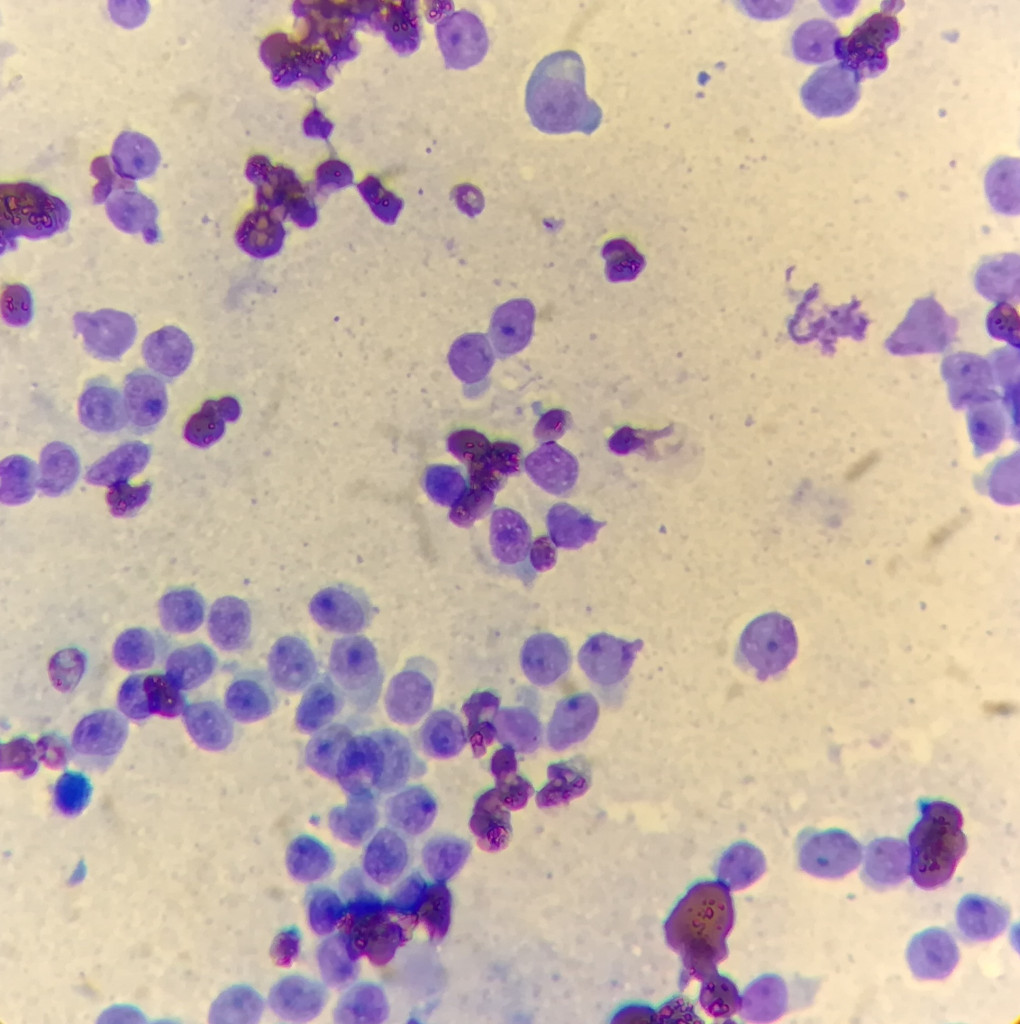
Фото 5 Фото 5

Введение
Гистиоциты – собирательный термин, включающий в себя макрофаги и несколько линий дендритных клеток, к которым относятся клетки Лангерганса и интерстициальные дендритные клетки. Гистиоциты происходят из гемопоэтической стволовой клетки CD341 и в дальнейшем дифференцируются в различные линии дендритных клеток и макрофагов1.Клетки Лангерганса встречаются в эпителии кожи, а также в пищеварительном тракте, дыхательных путях и репродуктивных органах. Интерстициальные дендритные клетки по преимуществу располагаются периваскулярно и находятся в большинстве органов, кроме головного мозга, хотя они встречаются в мозговых оболочках и сосудистом сплетении. Наиболее хорошо изучены дендритные клетки, встречающиеся в коже. К ним относятся эпидермальные клетки Лангерганса и дермальные дендритные клетки, которые являются интерстициальными дендритными клетками2.
Пролиферативные гистиоцитарные заболевания (гистиоцитозы) – группа заболеваний, обусловленных патологической пролиферацией дендритных клеток (интерстициальных дендритных клеток, клеток Лангерганса), а также макрофагов. Данные заболевания относительно часто встречаются у собак и реже – у кошек. Классификация их достаточно сложна и меняется с течением времени (табл. 1). У собак и кошек пролиферативные гистиоцитарные заболевания протекают как неопластические процессы, у собак еще и как воспалительные патологии с нарушением работы иммунной системы3.
В рамках данной статьи на примере двух клинических случаев более детально будет рассмотрен реактивный кожный гистиоцитоз у собак.
Реактивный гистиоцитоз (как местный, так и системный) описан только у собак, у кошек аналогичного состояния не выявлено. Реактивный кожный гистиоцитоз обусловлен активацией интерстициальных дендритных клеток и развивается как воспалительное заболевание с инфильтрацией кожи большим количеством лимфоцитов и гистиоцитов. Точная этиология и патогенез этого состояния неизвестны, однако предполагается, что причиной служит нарушение регуляции механизма иммунного ответа4.
Системный гистиоцитоз изначально был зарегистрирован у собак породы бернский зенненхунд5 как наследуемое заболевание. При этом гистиоцитарная саркома отмечалась в тех же линиях, что и системный гистиоцитоз, однако развития гистиоцитоза в саркому не было зарегистрировано. Системный гистиоцитоз встречается и у собак других крупных пород, однако в целом это редкая патология.
Кожный гистиоцитоз – более распространенное заболевание, впервые описанное как волнообразно протекающие дерматит и панникулит неизвестной этиологии, при этом в поражениях преобладали гистиоциты6.
Кожный и системный гистиоцитозы – родственные воспалительные заболевания. Считается, что первопричиной воспаления является антиген, однако выявить каких-либо возбудителей или антигены пока не удалось. В патологических очагах преобладают активированные интерстициальные дендритные клетки и Т-лимфоциты, которые зачастую инфильтрируют стенки кровеносных сосудов дермы и приводят к лимфогистиоцитарному васкулиту4. Роль Т-лимфоцитов в патогенезе кожного гистиоцитоза не ясна. При наличии кожных гистиоцитом эти клетки приводят к регрессии поражений, в случае же кожного гистиоцитоза они могут участвовать в пролиферации и активации дендритных клеток через цитокины Т-клеточного происхождения4,7.
Гипотеза о том, что в основе патогенеза данных заболеваний лежит нарушение иммунорегуляции, подтверждается особенностями клинического течения и ответом на терапию. Обе патологии характеризуются волнообразным течением с периодами ремиссий, особенно в начале болезни. К тому же пациенты и с кожным, и с системным гистиоцитозом склонны к спонтанному выздоровлению, что затрудняет адекватную оценку эффективности проводимой терапии. Тем не менее единственным эффективным методом лечения данных патологий является использование иммуномодуляторов и иммуносупрессантов8,9.
Реактивный кожный гистиоцитоз – воспалительное пролиферативное лимфогистиоцитарное заболевание, которое вовлекает преимущественно кожу и подкожную жировую клетчатку4. Частота вовлечения регионарных лимфоузлов неизвестна, поскольку их, как правило, не удаляют для гистологического исследования, если нет выраженной лимфаденопатии. Однако случаи поражения лимфоузлов отмечены в исследованиях.
Кожный гистиоцитоз встречается у представителей многих пород и их метисов; явной породной либо половой предрасположенности не выявлено4,6,9. Средний возраст животных на момент возникновения заболевания – от 2 до 13 лет9. Кожный гистиоцитоз проявляется внутрикожными и подкожными узлами и бляшками до 4 см в диаметре, покрытыми шерстью либо бесшерстными; поражения часто изъязвляются. Очаги могут спонтанно исчезать и появляться вновь на прежних местах или в новых областях. Наиболее часто поражения регистрируются на голове, морде (спинка носа и ушные раковины), на конечностях (включая подушечки) и туловище. У интактных самцов часто вовлечена мошонка6,9. Также отмечается поражение носового зеркала и ноздрей с эритемой, отеком и депигментацией10. В редких случаях, кроме кожи, вовлекаются другие органы и ткани. К примеру, в одной статье11 описан клинический случай потери зрения, вызванной реактивным гистиоцитозом с вовлечением орбиты, зрительного нерва и сетчатки у самца бордер-колли. Множественные кожные поражения у этого пациента регистрировались ранее и прошли самостоятельно, без терапии.
Описаны случаи прогрессирования реактивного кожного гистиоцитоза до системного4,12,13.
Цитологически кожный гистиоцитоз схож с гранулематозным воспалением. Популяция клеток представлена гистиоцитами с обильной цитоплазмой, зачастую содержащей мелкие вакуоли, округлыми или зубчатыми ядрами с плохо различимыми ядрышками. Также могут встречаться различные воспалительные клетки. Гигантские клетки и фагоцитоз эритроцитов встречаются редко.
Гистологически очаги, располагающиеся в дерме и подкожной клетчатке, содержат плеоцеллюлярный инфильтрат с преобладанием гистиоцитов. Также наблюдаются лимфоциты (преимущественно Т-клетки) и некоторое количество нейтрофилов. Часто отмечаются фолликулотропизм и сосудистая инвазия; эпидермотропизм, как правило, не выражен. В отличие от гистологической картины при гистиоцитомах вышележащий эпидермис обычно не имеет выраженной гиперплазии14.
Диагноз «реактивный кожный гистиоцитоз» ставится на основании совокупности данных анамнеза, клинических признаков, результатов цитологического и гистологического исследований. Для дифференцировки макрофагов и дендритных клеток и определения происхождения дермальных дендритных клеток проводится иммуногистохимия.
Следует дифференцировать реактивный кожный гистиоцитоз и другие заболевания, вызывающие гранулематозное воспаление (такие как глубокая пиодерма, дерматофития, синдром стерильной гранулемы/пиогранулемы), а также неэпителиотропную воспалительную лимфому кожи.
Клинический случай № 1
В клинику обратились владельцы интактного самца ирландского волкодава 5,5 лет с жалобами на узелковый дерматит у питомца. На момент обращения заболевание длилось третий месяц, были незначительные улучшения при лечении комплексным препаратом, содержащим триамцинолон, а также амоксициллином с клавулановой кислотой. Владельцы отметили волнообразный характер течения заболевания с периодами улучшения и ухудшения независимо от применяемого лечения. Также во время обострения у собаки отмечалось более шумное дыхание и чихание. Ранее дерматологических проблем не наблюдалось.По результатам осмотра были выявлены множественные отдельно расположенные и сливающиеся эритематозные узлы и бляшки размером до 1,5 см, расположенные на спине, боках, конечностях, хвосте и морде (вовлечены ушные раковины, спинка носа, крылья носа), а также на мошонке (фото 1-3). Зуда не отмечалось. Стандартные тесты (ЛЮМ-диагностика, соскобы, трихоскопия) оказались отрицательными. Цитологическое исследование мазков, полученных с помощью тонкоигольной биопсии, показало нейтрофильно-макрофагальное воспаление, также наличие в большом количестве клеток с круглым центрально и парацентрально расположенным ядром и скудной слабо базофильно окрашенной цитоплазмой, присутствие единичных, свободно лежащих кокков.
Поскольку основными предполагаемыми диагнозами были «реактивный кожный гистиоцитоз» и «синдром стерильной гранулемы/пиогранулемы», было принято решение о проведении биопсии с отбором материала для бактериологического посева и гистологического исследования.
На основании результатов бактериологического посева (табл. 2) было решено начать антибиотикотерапию доксициклином в суточной дозе 10 мг/кг. Терапия доксициклином продолжалась в течение трех недель и не дала видимого эффекта. Вследствие усиления таких симптомов, как затрудненное дыхание и чихание из-за вовлечения в процесс слизистой носовых ходов, до результатов гистологического исследования в качестве пробной симптоматической терапии был назначен оклацитиниб (торговое название «Апоквел») в дозе 0,4 мг/кг 2 раза в сутки. На фоне оклацитиниба быстро наступило значимое улучшение кожных и дыхательных симптомов.
Гистологическое заключение
Микроскопическое описание. На стекле представлены два серийных среза четырех крупных образцов кожи. Отмечаются обширные участки плотной инфильтрации дермы. Участки слабо отграничены от смежных тканей, более расположены вокруг волосяных фолликулов и в поверхностной дерме. Отмечается инфильтрация эпидермиса. Большая часть клеток, схожих с гистиоцитами, имеет неправильную или слегка вытянутую форму, обильную, часто вспененную светлую эозинофильную цитоплазму. Клеточные границы не всегда хорошо просматриваются. Ядра крупные, овальной или слегка неправильной формы, со светлым глыбчатым хроматином и крупными малиновыми ядрышками. Количество митозов 6 в 2,37 мм2. Клетки распространяются в гиподерму, окружают кровеносные сосуды. Также присутствуют многочисленные нейтрофильные лейкоциты, тучные клетки, малые лимфоциты. При окраске PAS и по Цилю – Нильсену специфические антигены не обнаруживаются.Морфологический диагноз (кожа): гистиоцитарная инфильтрация дермы, многоочаговая, в основном вокруг аднексальных структур и в поверхностной дерме.
Диагноз (кожа): гистиоцитарные заболевания (более вероятно).
Комментарий: присланные образцы имеют признаки выраженного смешанного воспаления и обильной инфильтрации гистиоцитами без выраженных признаков атипии. Основными дифференциальными диагнозами в данном случае являются: кожный гистиоцитоз клеток Лангерганса, кожный реактивный гистиоцитоз и неэпителиотропная воспалительная лимфома кожи. Инфекционные агенты при окраске PAS и по Цилю – Нильсену не выявляются.
Кожный реактивный гистиоцитоз – это воспалительное пролиферативное гистиоцитарное заболевание, которое обычно затрагивает кожу и подкожную клетчатку. Поражения не распространяются за пределы лимфатических узлов. При поражении внутренних органов данное состояние характеризуется как системный гистиоцитоз.
По результатам гистологического исследования и общего обследования (отсутствие значимых отклонений в биохимическом и клиническом анализах крови, при обзорном УЗИ брюшной полости) с учетом положительного ответа на терапию оклацитинибом был поставлен окончательный диагноз «реактивный кожный гистиоцитоз» и предложена дальнейшая терапия оклацитинибом.
На фоне лечения, продлившегося в течение трех месяцев, кожные симптомы полностью не ушли (оставались слабо заметные бляшки на спинке носа и грудных конечностях). При попытке снизить дозу до 0,4 мг/кг 1 раз в сутки произошел рецидив. Использование метилпреднизолона привело к быстрому развитию выраженной полиурии и полидипсии без значимой положительной динамики. В связи с этим было решено перейти на терапию циклоспорином в дозе 6 мг/кг в сутки. В дальнейшем на протяжении четырех месяцев симптомы хорошо контролировались приемом циклоспорина – 6 мг/кг в сутки 5 дней в неделю. Затем связь с пациентом прекратилась.
Клинический случай № 2
В клинику обратились владельцы интактного самца породы чихуахуа 11,5 лет с жалобами на появление у питомца узелковой сыпи без признаков зуда. Поражения заметили за 3 дня до приема. Ранее обращались в клинику с жалобами на новообразование в области анального отверстия (была цитологически диагностирована аденома гепатоидных желез, запланирована кастрация). Иных жалоб на самочувствие не было. За месяц до дерматологического осмотра пациент проходил плановое обследование, в ходе которого отклонений выявлено не было. Биохимический и клинический анализы крови также не показали значимых изменений.По результатам осмотра были обнаружены множественные эритематозные узлы и бляшки от 3 до 8 мм, расположенные преимущественно на спине (фото 4). Аналогичные единичные поражения располагались на боках, тазовых конечностях и животе.
В цитологии мазков, полученных посредством ТИБ, была выявлена мономорфная популяция клеток с округлым ядром и слабо базофильной цитоплазмой (фото 5). Предполагаемые диагнозы – «реактивный кожный гистиоцитоз», «круглоклеточные опухоли кожи». Было принято решение о проведении биопсии кожи с последующим гистологическим исследованием образцов. Поскольку жалоб на самочувствие не было, начало терапии было отложено до получения результатов гистологического исследования.
Гистологическое заключение
Новообразование кожи. На стекле представлены множественные серийные срезы двух образцов кожи с новообразованиями. Новообразования однотипны и будут описаны как одно, расположены в поверхностной дерме, слегка расширяя ее, в непосредственной близости к эпидермису, инвазируя зону Гренца. Новообразования слабо отграничены от смежных тканей, распространяются в толщу дермы, кровеносные сосуды выглядят непораженными. Неопластические клетки лежат пластами, разделенными коллагеновыми волокнами дермы, имеют округлую или неправильную форму, клеточные границы в основном слабо просматриваются. Цитоплазма скудного количества, светлая. Ядра крупные, расположены центрально, округлой или слегка неправильной формы, со слабозернистым хроматином и округлыми малиновыми ядрышками. Количество митозов 12 в 2,37 мм2. Немногочисленные малые лимфоциты.Дополнительные срезы. Представлено два серийных среза трех образцов новообразований кожи.
Инфильтрация в толще дермы выглядит плотной, однородной. Кровеносные сосуды немногочисленные, окружены неопластическими клетками. Не отмечено четких признаков ангиоцентризма.
Морфологический диагноз (новообразования кожи): круглоклеточные новообразования.
Диагноз (новообразования кожи): круглоклеточные новообразования.
Комментарий. Новообразования кожи однотипные – это круглоклеточные новообразования. Могут являться вариантом гистиоцитарных заболеваний – системного или кожного гистиоцитоза, однако нетипично отсутствие поражений кровеносных сосудов (просматриваются лишь единичные кровеносные сосуды в глубокой дерме). Также не исключены варианты лимфомы.
Через две недели поражения самостоятельно регрессировали без лечения. На основании этого факта и результатов гистологического исследования был поставлен окончательный диагноз «реактивный кожный гистиоцитоз».В дальнейшем на протяжении года наблюдения рецидива заболевания не происходило.
Обсуждение
Реактивный кожный гистиоцитоз считается заболеванием, связанным с нарушением иммунорегуляции, и поэтому терапия данной патологии должна включать иммуномодуляторы и иммунодепрессанты8,9. Антибиотики показали свою неэффективность6,12,15.Хирургическое лечение помогает избавиться от патологических очагов, однако не предотвращает появление новых поражений6,12. Большинство собак хорошо отвечает на терапию иммуносупрессивными дозами кортикостероидов6,9,12. Лефлуномид, циклоспорин и азатиоприн тоже эффективны, в том числе в случае недостаточной эффективности кортикостероидов4,9,12. В том числе описаны случаи положительной динамики при комбинированной терапии тетрациклином и ниацинамидом9. Местное лечение, включающее кортикостероиды, также может быть эффективным при наличии локализованных поражений. Многие собаки уходят в ремиссию (в том числе без лечения), однако для большего количества пациентов требуется поддерживающая терапия с целью предотвращения рецидивов. Описана взаимосвязь высокого риска развития рецидивов у собак с вовлечением в процесс области мочки носа и носового зеркала9.
В качестве начальной терапии пациента № 1 использовался оклацитиниб (торговое название «Апоквел») – неселективный ингибитор янус-киназы (JAK). Изначально оклацитиниб позиционировался как средство для контроля зуда. Препарат угнетает функции провоспалительных, проаллергических и пруритогенных (приводящих к возникновению зуда) цитокинов, зависимых от ферментативной активности JAK1 или JAK3 (в основном пруритогенный IL-31). В результате подавляются ключевые механизмы возникновения зуда, ассоциированного с аллергией, а также устраняются симптомы местного воспаления16. Однако дальнейшие исследования показали, что оклацитиниб может использоваться как альтернативный иммуносупрессант при целом ряде патологий17,18. У данного пациента оклацитиниб давал хороший результат в суточной дозе 0,8 мг/кг, но снижение дозы привело к рецидиву. Возможно, использование высоких доз способствовало бы полной ремиссии на фоне лечения, однако достоверных данных о побочных эффектах при длительном применении высоких доз оклацитиниба нет. Тем не менее этот препарат очень перспективен как иммуносупрессант при различных иммуноопосредованных заболеваниях.
Реактивный кожный гистиоцитоз может разрешаться спонтанной полной или частичной ремиссией без лечения. Подобные случаи описаны в литературе4,9,11,12. Самовыздоровление без последующих рецидивов наблюдалось и у пациента № 2.
Заключение
Реактивный кожный гистиоцитоз – нечасто встречающееся в клинической практике воспалительное заболевание кожи, связанное с инфильтрацией дермы и подкожной клетчатки гистиоцитами. Болезнь может спонтанно регрессировать, может иметь волнообразный характер течения с периодами улучшений, может потребовать поддерживающего лечения на продолжительный период времени, может прогрессировать до системного гистиоцитоза.В большинстве случаев единственная эффективная терапия предполагает использование иммуномодуляторов (в том числе и альтернативных, таких как оклацитиниб) зачастую в качестве пожизненного лечения. В связи с этим, а также с учетом сходства клинических проявлений с симптомами инфекционных и опухолевых заболеваний диагностика кожного гистиоцитоза должна проводиться как можно более полно и включать гистологическое исследование кожных биоптатов, а также проведение иммуногистохимии при необходимости. Кроме того, следует учитывать то, что кожные проявления системной формы реактивного гистиоцитоза аналогичны симптомам при кожном гистиоцитозе. Поэтому всегда стоит исключать наличие системного процесса, особенно у представителей предрасположенных пород.
Список литературы:
- Cline M. J. Histiocytes and histiocytosis. Blood, 84(9): 2840–53, 1994.
- Merad M., Ginhoux F., Collin M. Origin, homeostasis and function of Langerhans cells and other langerin-expressing dendritic cells. Nat Rev Immunol, 8(12): 935–47, 2008.
- Moore P. F. A review of histiocytic diseases of dogs and cats. Vet Pathol, 51(1): 167–84, 2014.
- Affolter V. K., Moore P. F. Canine cutaneous and systemic histiocytosis: reactive histiocytosis of dermal dendritic cells. Am J Dermatopathol, 22(1): 40–8, 2000.
- Moore P. F. Systemic histiocytosis of Bernese mountain dogs. Vet Pathol, 21(6): 554–63, 1984.
- Mays M. B., Bergeron J. A. Cutaneous histiocytosis in dogs. J Am Vet Med Assoc, 188(4): 377–81, 1986.
- Shortman K., Naik S. H. Steady-state and inflammatory dendritic-cell development. Nat Rev Immunol, 7(1): 19–30, 2007.
- Moore P. F. Histiocytic proliferative diseases. In: Weiss D. J., Wardrop K. J., eds. Schalm’s Veterinary Hematology. 6th ed. Ames, IA: Wiley-Blackwell, 2010.
- Palmeiro B. S., Morris D. O., Goldschmidt M. H., et al. Cutaneous reactive histiocytosis in dogs: a retrospective evaluation of 32 cases. Vet Dermatol, 18(5): 332–40, 2007.
- Moore P. F. Histiocytic Diseases. Veterinary Clinics of North America: Small Animal Practice, 53(1): 121–140, Jan 2023.
- Pumphrey S. A., Pizzirani S, Pirie C. G., Sato A. F., Buckley F. I. Reactive histiocytosis of the orbit and posterior segment in a dog. Vet Ophthalmol, 16(3): 229–33, May 2013.
- Affolter V. K., Moore P. Canine cutaneous histiocytic diseases. In: Bonagura J. D., ed. Kirk’s Current Veterinary Therapy XIII: Small Animal Practice. Philadelphia, PA: W. B. Saunders, 588–91, 2000.
- Affolter V. K., Moore P. F. Histiocytes in skin disease. In: Thoday K. L., Foil C. S., Bond R., eds Advances in Veterinary Dermatology, 4th edn. Oxford, UK: Blackwell Science, 111–30, 2002.
- Scott D. W., Miller W. H., Griffin C. E. Neoplastic and Non-Neoplastic Tumors. Muller and Kirk’s Small Animal Dermatology, 7th ed, WB Saunders, P. 819, 2012.
- Thornton R. N., Tisdall C. J. Multiple cutaneous histiocytosis in two dogs. New Zealand Veterinary Journal, 36: 192–3, 1988.
- Gonzales A. J., Bowman J. W., Fici G. J., Zhang M., Mann D. V., Mitton-Fry M. Oclacitinib (APOQUEL(®)) is a novel Janus kinase inhibitor with activity against cytokines involved in allergy. J Vet Pharmacol Ther, 37(4): 317–24, Aug 2014.
- Colombo S., Cornegliani L., Vercelli A., Fondati A. Ear tip ulcerative dermatitis treated with oclacitinib in 25 dogs: a retrospective case series. Vet Dermatol, 32(4): 363-e100, Aug 2021.
- Levy B. J., Linder K. E., Olivry T. The role of oclacitinib in the management of ischaemic dermatopathy in four dogs. Vet Dermatol, 30(3): 201-e63, Jun 2019.

vetpeterburg
vetpeterburg Ветеринарный Петербург
Ветеринарный Петербург